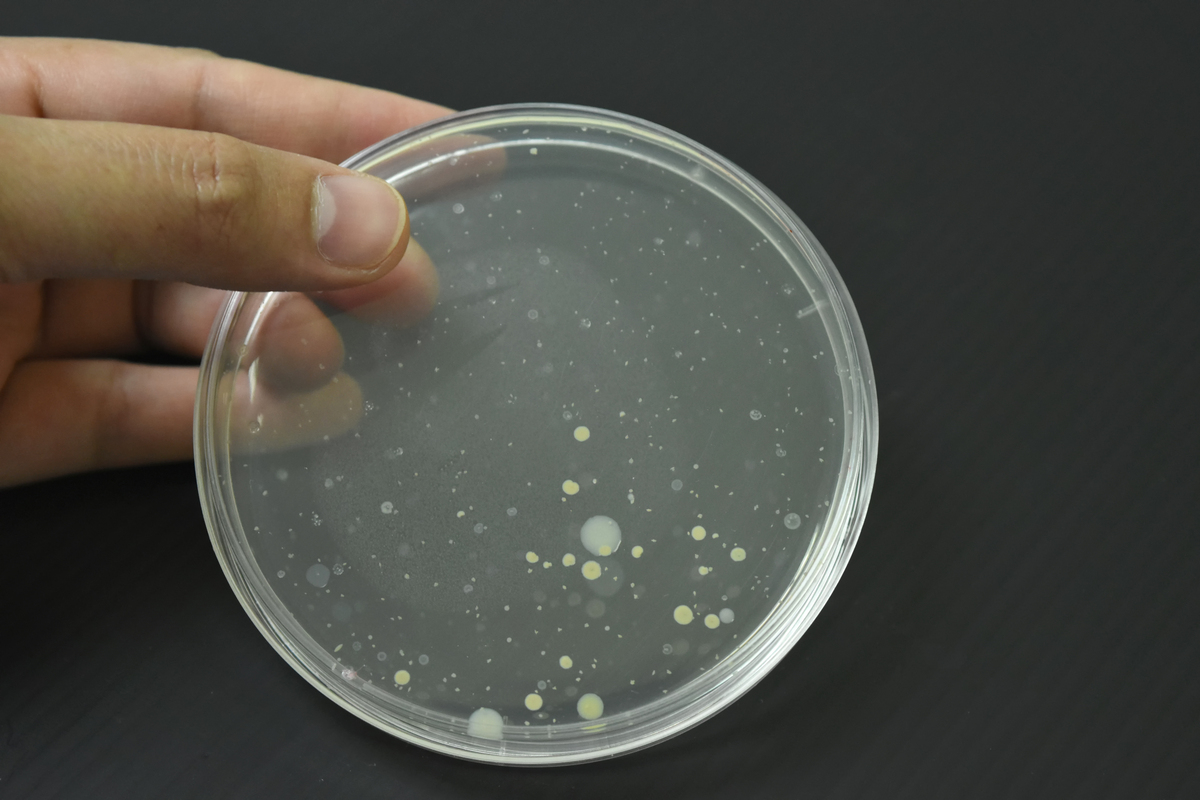
lb培养基配方

lb培养基配方
以下是一种常见的LB培养基配方:
- 琼脂:10 g
- 蛋白胨:10 g
- 热水:1 L
- NaCl:10 g
将琼脂和蛋白胨加入热水中,加热搅拌至溶解。加入NaCl并调pH至7.0左右。将溶液分装入培养皿中,待凝固后即可使用。
需要注意的是,不同实验室可能会根据自身需要对配方进行微调,如加入不同的添加剂、改变pH值等。因此,在使用LB培养基前最好查看实验室的具体配方。

原文地址: http://www.cveoy.top/t/topic/fPiO 著作权归作者所有。请勿转载和采集!
安全问答是一个知识全球问答,包含丰富的问答知识
以下是一种常见的LB培养基配方:
将琼脂和蛋白胨加入热水中,加热搅拌至溶解。加入NaCl并调pH至7.0左右。将溶液分装入培养皿中,待凝固后即可使用。
需要注意的是,不同实验室可能会根据自身需要对配方进行微调,如加入不同的添加剂、改变pH值等。因此,在使用LB培养基前最好查看实验室的具体配方。
原文地址: http://www.cveoy.top/t/topic/fPiO 著作权归作者所有。请勿转载和采集!